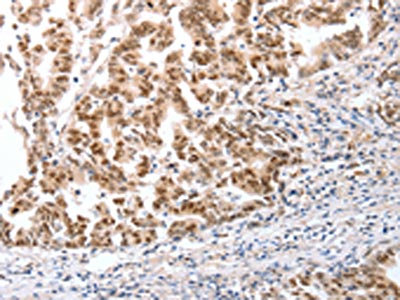

CTBP2 Antibody
-
中文名稱:CTBP2兔多克隆抗體
-
貨號:CSB-PA784650
-
規格:¥1100
-
圖片:
-
The image on the left is immunohistochemistry of paraffin-embedded Human gastic cancer tissue using CSB-PA784650(CTBP2 Antibody) at dilution 1/25, on the right is treated with fusion protein. (Original magnification: ×200)
-
The image on the left is immunohistochemistry of paraffin-embedded Human ovarian cancer tissue using CSB-PA784650(CTBP2 Antibody) at dilution 1/25, on the right is treated with fusion protein. (Original magnification: ×200)
-
-
其他:
產品詳情
-
Uniprot No.:
-
基因名:
-
別名:C terminal binding protein 2 antibody; C-terminal-binding protein 2 antibody; CtBP2 antibody; CTBP2_HUMAN antibody; ribeye antibody
-
宿主:Rabbit
-
反應種屬:Human,Mouse,Rat
-
免疫原:Fusion protein of Human CTBP2
-
免疫原種屬:Homo sapiens (Human)
-
標記方式:Non-conjugated
-
抗體亞型:IgG
-
純化方式:Antigen affinity purification
-
濃度:It differs from different batches. Please contact us to confirm it.
-
保存緩沖液:-20°C, pH7.4 PBS, 0.05% NaN3, 40% Glycerol
-
產品提供形式:Liquid
-
應用范圍:ELISA,IHC
-
推薦稀釋比:
Application Recommended Dilution ELISA 1:2000-1:5000 IHC 1:25-1:100 -
Protocols:
-
儲存條件:Upon receipt, store at -20°C or -80°C. Avoid repeated freeze.
-
貨期:Basically, we can dispatch the products out in 1-3 working days after receiving your orders. Delivery time maybe differs from different purchasing way or location, please kindly consult your local distributors for specific delivery time.
-
用途:For Research Use Only. Not for use in diagnostic or therapeutic procedures.
相關產品
靶點詳情
-
功能:Corepressor targeting diverse transcription regulators. Functions in brown adipose tissue (BAT) differentiation.; Isoform 2 probably acts as a scaffold for specialized synapses.
-
基因功能參考文獻:
- the present study indicated that CtBP2 reduced the susceptibility of ECA109 cells to cisplatin by regulating the expression of apoptosis-related proteins, suggesting that it may be a promising therapeutic target in esophageal squamous cell carcinoma in the future. PMID: 29658564
- Results indicated that CTBP2 was direct target of miR-338-5p in glioma cells. CTBP2 silencing can rescued the phenotype changes induced by miR-338-5p inhibitor on cell proliferation and invasion in glioma. PMID: 28826173
- this study shows that CtBP2 overexpression promotes tumor cell proliferation and invasion in gastric cancer and is associated with poor prognosis PMID: 28404932
- these findings provide insight into the role CtBP2 plays in promoting proliferation and migration in breast cancer by the inhibition of p16INK4A. PMID: 28412731
- CtBP2 ameliorated palmitic acid-induced insulin resistance via ROS-dependent JNK pathway. PMID: 28111233
- CtBP2 is a druggable transforming oncoprotein critical for the evolution of neoplasia driven by Apc mutation. PMID: 28414304
- CtBP2 may be a potential target to suppress tumorigenesis in neuroblastoma PMID: 28179207
- This Gene-based tests suggest evidence of association with related genes, ZEB2, RND3, MCTP1, CTBP2, and beta EEG PMID: 28040410
- Our results indicated that CCNH/CDK7-CtBP2 axis may augment ESCC cell migration, and targeting the interaction of both may provide a novel therapeutic target of esophageal squamous cell carcinoma . PMID: 25820824
- Releasing the key adipogenic regulator C/EBPalpha from CtBP2 binding. PMID: 25895816
- Enhanced CtBP2expression promoted HCC xenograft growth and induced EMT. PMID: 25686837
- results show how CtBP2 contributes to prostate cancer progression by modulating AR and oncogenic signaling PMID: 25228652
- High CTBP2 expression is associated with prostate cancer. PMID: 24332637
- Overexpression of CtBP2 is associated with breast carcinoma. PMID: 24522810
- CtBP2 might contribute to the progression of esophageal squamous cell carcinoma through a negative transcriptional regulation of p16(INK4A). PMID: 23255392
- CtBP2 is over-expressed in prostate cancer.CtBP2 promotes prostate cancer cell proliferation through c-Myc signaling. PMID: 24835310
- BRCA1 expression is epigenetically repressed in sporadic ovarian cancer cells by overexpression of C-terminal binding protein 2.CtBP2 is an ovarian cancer oncogene. PMID: 23730208
- CtBP2 directly targeted stem cell core genes resulting in increased cancer cell stemness and increasing metastatic and tumorigenic potential. PMID: 24012420
- E2F7 recruits the co-repressor C-terminal-binding protein (CtBP) and that CtBP2 is essential for E2F7 to repress E2F1 transcription. PMID: 23853115
- CTBP2 is a transcriptional cofactor for RXR-alpha/RAR-alpha. PMID: 23775127
- We propose that CtBP2 is an ovarian cancer oncogene that regulates gene expression program by modulating HDAC activity. PMID: 22945647
- these data demonstrate that CHIP regulates the steady-state level of CtBP2 as an E3 ubiquitin ligase and determines the expression levels of CtBP2 target genes. PMID: 23410750
- Interaction with cyclin H/cyclin-dependent kinase 7 (CCNH/CDK7) stabilizes C-terminal binding protein 2 (CtBP2) and promotes cancer cell migration PMID: 23393140
- Doubly transgenic zebrafish exhibit a startle response and typical swimming behavior, indicating that there is no gross disruption of either hearing or vestibular function useful in the study of ribbon synapse development of the hair cell. PMID: 21334379
- This study demonstrates that ataxin-1 occupies the promoter region of E-cadherin in vivo and that ataxin-1 activates the promoter in a CtBP2-mediated transcriptional regulation manner. PMID: 21315774
- we demonstrate that it is the interaction of CtBPs with transcriptional regulators and/or chromatin-modifying enzymes in the cell nucleus, rather than their role in Golgi fission, which is critical for the maintenance of mitotic fidelity. PMID: 21057548
- CtBP2 proteins are ubiquitously expressed in all lines and tumour samples. PMID: 20964627
- CtBP2 selectively down-regulates Th2 cytokines, therefore it is a potential target for the treatment of allergic diseases. PMID: 20523059
- Data suggest that ARF antagonism of CtBP repression of Bik and other BH3-only genes may have a critical role in ARF-induced p53-independent apoptosis and tumor suppression. PMID: 19798104
- roles of acetylation in regulating subcellular localization and transcriptional activity of CtBP2. PMID: 16356938
- analysis of the CtBP2 corepressor complex induced by E1A and modulation of E1A transcriptional activity by CtBP2 PMID: 17023432
- E1A may gain access to cellular promoters through conservved sequence-dependent interaction with CtBP2. PMID: 17546044
- Study shows that transcription corepressor CtBP2 directly binds acinus, which is regulated by nerve growth factor (NGF), inhibiting its stimulatory effect on cyclin A1, but not cyclin A2, expression in leukemia. PMID: 19668232
- CtBP2 monomer interacts with a major CtBP-dependent repressor ZEB and HDAC and that the interaction of the two factors with the CtBP2 monomer was mutually exclusive. PMID: 19754958
- Genome-wide association study of gene-disease association. (HuGE Navigator) PMID: 18264096
顯示更多
收起更多
-
亞細胞定位:Nucleus. Cell junction, synapse.
-
蛋白家族:D-isomer specific 2-hydroxyacid dehydrogenase family
-
組織特異性:Ubiquitous. Highest levels in heart, skeletal muscle, and pancreas.
-
數據庫鏈接:
Most popular with customers
-
-
YWHAB Recombinant Monoclonal Antibody
Applications: ELISA, WB, IHC, IF, FC
Species Reactivity: Human, Mouse, Rat
-
Phospho-YAP1 (S127) Recombinant Monoclonal Antibody
Applications: ELISA, WB, IHC
Species Reactivity: Human
-
-
-
-
-